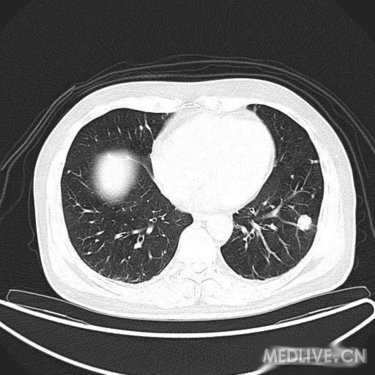
【影像读片】两肺多发性结节---罕见病例,长见
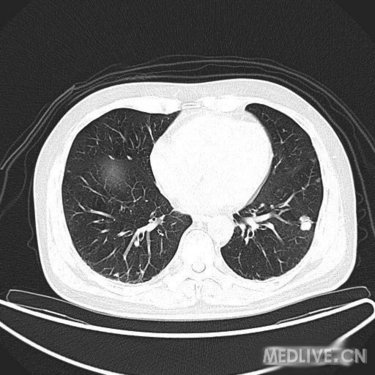
【影像读片】两肺多发性结节---罕见病例,长见

一例萜烯诺卡菌肺炎的实验室诊断
464x318 - 40KB - JPEG

乳腺结节能消除吗 乳房多发性结节怎么办
334x240 - 100KB - PNG

【甲状腺多发性结节的治疗】_结节_怎么办_表
500x346 - 34KB - JPEG

甲状腺多发性结节危害_甲亢频道_健客网
400x300 - 12KB - JPEG
【影像读片】两肺多发性结节---罕见病例,长见
375x375 - 32KB - JPEG

多发性乳腺结节严重吗_多发性乳腺结节怎么办
189x284 - 6KB - JPEG

多发性甲状腺结节严重吗?
900x500 - 25KB - JPEG

【甲状腺多发性结节 】_甲状腺多发性结节_怎
500x364 - 44KB - JPEG

【甲状腺多发性实性结节】_甲状腺_ 症状 _影
500x338 - 31KB - JPEG

甲状腺结节药品多发性甲状腺结节_乐族网
467x328 - 55KB - JPEG

如何判断多发性甲状腺结节是良性的?
389x416 - 30KB - JPEG

多发性甲状腺结节都是良性的吗_寻医问药网
179x220 - 4KB - JPEG
【影像读片】两肺多发性结节---罕见病例,长见
375x375 - 31KB - JPEG

【乳腺多发性结节 】_乳腺_多发性结节_乳房健
500x335 - 21KB - JPEG

多发性乳腺结节痛怎么办 用啥方法可以调理
500x308 - 215KB - PNG
多发性结节是甲状腺结节的一种。甲状腺结节是一种非常常见的病症,特别是在中年女性中较多见。甲状腺结节分良性及恶性两大类,良性结节占绝大多数,恶性结节不足1%。临
太平洋亲子网症状库提供多发性结节原因、诊断、治疗等信息,让您全面了解多发性结节病因、相关疾病、检查诊断、治疗护理、预防保健及其他相关知识。 您现在的位置:母
你好,乳腺多发性结节大多是内分泌失调引起的,属于良性病变,生长缓慢,主要是月经前乳房疼痛加重,月经后症状减轻或者消失。可以用硫酸镁局部热敷,口服乳癖消治疗,平时不要
好大夫问答知识库【多发性结节】页面汇总了和多发性结节内容相关的、患者在好大夫在线咨询过的问题。如果你也有多发性结节相关方面的问题,不妨先来多发性结节页面看
多发性结节的原因有哪些?有问必答网多发性结节症状查询频道为您解答多发性结节是怎么引起的,可由甲状腺退行性变、炎症、自身免疫以及新生物等多种病变所致。. 症状百
我的建议是手术。最大结节为5.8cm大小,且超声提示结节处皆见血流信号,这个结果则说明了结节是活性的,在血的供应下,很有可能会持续性的增长,造成了结节压迫器官,造成呼
,平时经常加班熬夜,还有很多人经常抽烟喝酒,而且平时缺乏运动,这些诸多原因导致肺部结节发病率越来越高,下面为大家详细介绍多发性肺结节这
你好,根据你身体患有甲状腺多发结节的情况,有必要在医生指导下,根据身体情况采取。活血化瘀散结的药物,或者是微创手术的方法进行规范治疗